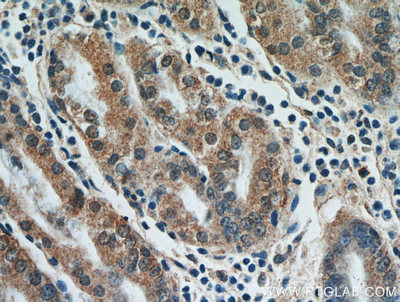

ANTI-FAM101A ,Each
$ 568.08
|
|
Details:
Anti-FAM101A^ Anti-FAM101A Antibody, Host Species: Rabbit, Cross Reactivity: Human,Mouse,Rat, Immunogen: Fusion Protein, C-135 amino acid, Format:Antigen affinity purification, Application: ELISA, WB, IHC, Recommended Storage: - 20 C or lower
Additional Information
| SKU | 23452243 |
|---|---|
| UOM | EACH |
| UNSPSC | 12352203 |
| Manufacturer Part Number | 21113-1-AP |
| Product Dimensions | 8.25X7.25X4.74 Inches |
| Product Weight | 1.8 |
